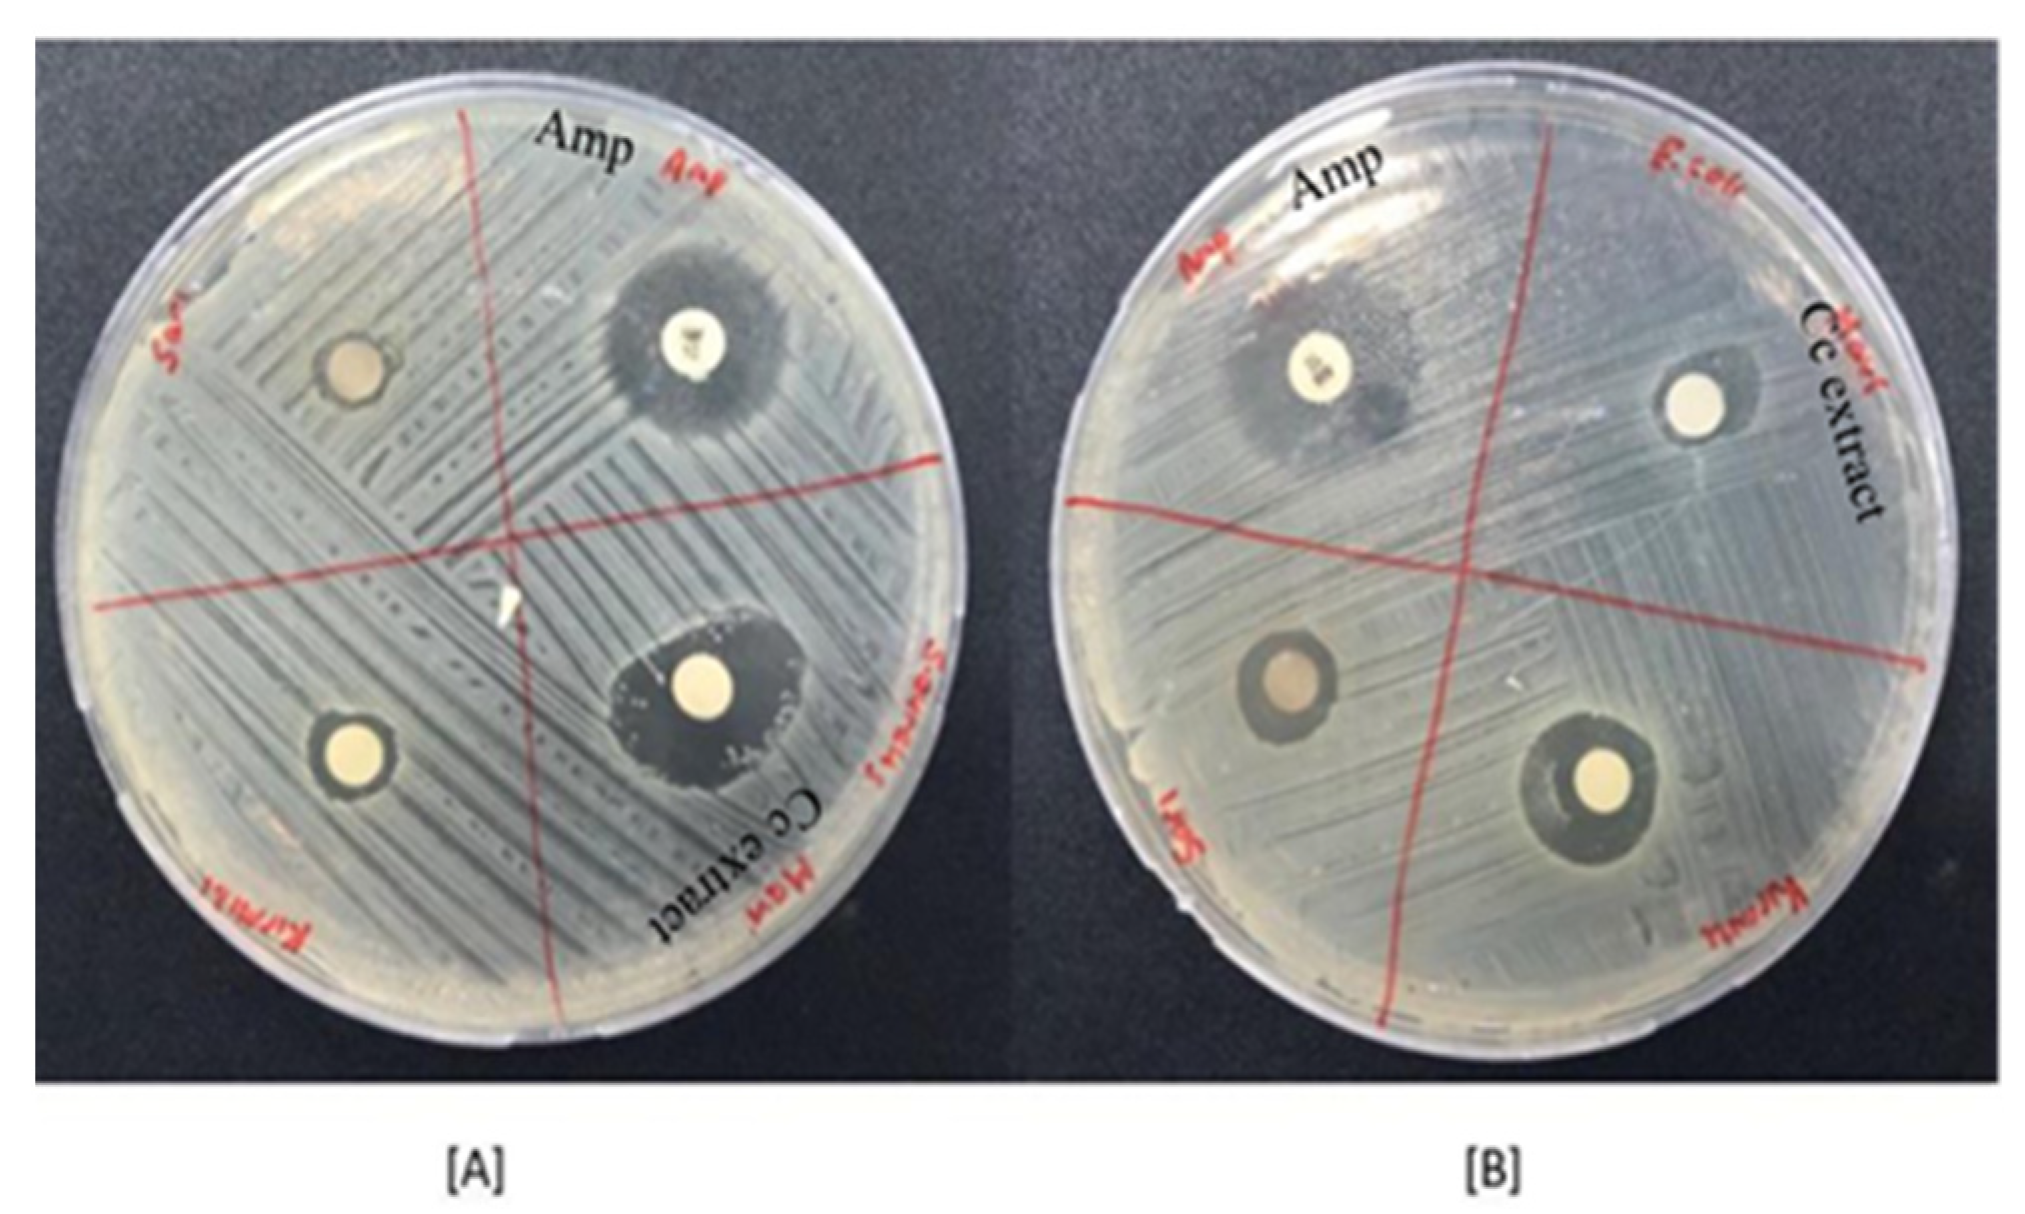
Gels 11 00264 g003

Investigation of PVA Matrix Hydrogel Loaded with Centaurea cyanus Extract for Wound Dressing Applications: Morphology, Drug Release, Antibacterial Efficiency, and In Vitro Evaluation
Abstract
1. Introduction
2. Results and Discussion
2.1. LC-MS Results
2.2. MTT Results
2.3. Antibacterial Activity Results
2.4. Characterization of Herbal Transdermal Patch
2.4.1. SEM
2.4.2. FTIR
2.4.3. Tensile Strength Test
2.4.4. Determination of Transdermal Patch Thickness
2.4.5. Weight Uniformity
2.4.6. Moisture Content Percentage
2.4.7. Percentage of Dehumidification
2.4.8. Percent Swelling Rate
2.4.9. Determination of Surface pH
2.4.10. In Vitro Release Profile
3. Conclusions
4. Materials and Methods
4.1. Materials
4.2. Synthesis Procedure
4.2.1. Plant Extract
4.2.2. Fabrication of Herbal Transdermal Patch
4.3. Characterization
4.3.1. LC-MS Method
4.3.2. MTT Test
4.3.3. Antibacterial Activity
4.3.4. Characterization of Herbal Transdermal Patch
SEM
FTIR
Tensile Strength Test
Determination of Film Thickness
Weight Uniformity
Moisture Content Percentage
Percentage of Dehumidification
Percent Swelling Rate
Determination of Surface pH
In Vitro Release Profile
Author Contributions
Funding
Institutional Review Board Statement
Informed Consent Statement
Data Availability Statement
Conflicts of Interest
References
- Liang, Y.; He, J.; Guo, B. Functional Hydrogels as Wound Dressing to Enhance Wound Healing. ACS Nano J. 2021, 15, 12687–12722. [Google Scholar] [CrossRef]
- Elias, P.M.; Feingold, K.R. Skin Barrier; Taylor & Francis: New York, NY, USA, 2006. [Google Scholar]
- Dąbrowska, A.K.; Spano, F.; Derler, S.; Adlhart, C.; Spencer, N.D.; Rossi, R.M. The Relationship between skin function, barrier properties, and body-dependent factors. Ski. Res. Technol. 2018, 24, 165–174. [Google Scholar] [CrossRef]
- Montagna, W. The Structure and Function of Skin; Elsevier: Amsterdam, The Netherlands, 2012. [Google Scholar]
- Eming, S.A.; Martin, P.; Tomic-Canic, M. Wound repair and regeneration: Mechanisms, signaling, and translation. Sci. Transl. Med. 2014, 6, 265sr6. [Google Scholar] [CrossRef] [PubMed]
- Ulusoy, A.; Dikmen, N. Hidrojellerin Tıpta Uygulamaları. Arşiv Kaynak Tarama Derg. 2020, 29, 129–137. [Google Scholar] [CrossRef]
- Prajapati, S.T.; Patel, G.C.; Patel, N.C. Formulation and Evaluation of Transdermal Patch of Repaglinide. ISRN Pharm. 2011, 13, 274–285. [Google Scholar] [CrossRef]
- Akhtar, M.F.; Hanif, M.; Ranjha, N.M. Methods of synthesis of hydrogels … A Review. Saudi Pharm. J. 2016, 24, 554–559. [Google Scholar] [CrossRef]
- Xu, Y.; Chen, H.; Fang, Y.; Wu, J. Hydrogel Combined with Phototherapy in Wound Healing. Adv. Healthc. Mater. 2022, 11, e2200494. [Google Scholar] [CrossRef]
- Gavan, A.; Colobatiu, L.; Hanganu, D.; Bogdan, C.; Olah, N.K.; Achim, M.; Mirel, S. Development and Evaluation of Hydrogel Wound Dressings Loaded with Herbal Extracts. Processes 2022, 10, 242. [Google Scholar] [CrossRef]
- Suntar, I. The Medicinal Value of Asteraceae Family Plants in Terms of Wound Healing Activity. FABAD J. Pharm. Sci. 2014, 39, 21–31. [Google Scholar]
- George Kallivalappil, G.; Kuttan, G. Evaluation of the anti inflammatory and urotoxicity ameliorative effects of gamma-humulene containing active fraction of Emilia sonchifolia (L.) DC. Inflammopharmacology 2019, 27, 409–420. [Google Scholar] [CrossRef]
- Ghaderi, A.; Sonboli, A. Chemical composition and antimicrobial activity of the essential oil of Tanacetum walteri (Anthemideae-Asteraceae) from Iran. Nat. Prod. Res. 2018, 33, 1787–1790. [Google Scholar] [CrossRef] [PubMed]
- Ozbilgin, S.; Akkol, E.K.; Ergene Oz, B.; Ilhan, M.; Saltan, G.; Acikara, O.B.; Tekin, M.; Keleş, H.; Suntar, I. In vivo activity assessment of some Tanacetum species used as traditional wound healer along with identification of the phytochemical profile by a new validated HPLC method. Iran. J. Basic Med. Sci. 2018, 21, 145–152. [Google Scholar] [CrossRef] [PubMed]
- Parente, L.M.; Lino Junior Rde, S.; Tresvenzol, L.M.; Vinaud, M.C.; DePaula, J.R.; Paulo, N.M. Wound healing and anti-inflammatory effect in animal models of Calendula officinalis L. growing in Brazil. Evid.-Based Complement. Altern. Med. 2012, 2012, 375671. [Google Scholar] [CrossRef]
- Nayak, B.S.; Ramlogan, S.; Chalapathi Rao, A.; Maharaj, S. Neurolaena lobata L. promotes wound healing in Sprague Dawley rats. Int. J. Appl. Basic Med. Res. 2014, 4, 106–110. [Google Scholar] [CrossRef]
- Speroni, E.; Govoni, P.; Guizzardi, S.; Renzulli, C.; Guerra, M.C. Anti inflammatory and cicatrizing activity of Echinacea pallida Nutt. root extract. J. Ethnopharmacol. 2002, 79, 265–272. [Google Scholar] [CrossRef]
- Rosa Ados, S.; Bandeira, L.G.; Monte-Alto-Costa, A.; Romana-Souza, B. Supplementation with olive oil, but not fish oil, improves cutaneous wound healing in stressed mice. Wound Repair Regen. 2014, 22, 537–547. [Google Scholar] [CrossRef]
- Takeda, K.; Tominaga, S. The Anthocyanin in Blue Flowers of Centaurea cyanus, The Botanical Magazine. J. Plant Res. 1983, 96, 359–363. [Google Scholar]
- Pirvui, L.; Bubueanu, C.; Panteli, M.; Petcu, L.; Coprean, D. Centaurea cyanus L. polysaccharides and polyphenols cooperation in achieving strong rat gastric ulcer protection. Open Chem. 2015, 13, 910–921. [Google Scholar]
- Hazırı, A.; Faiku, F.; Rudhani, İ.; Mehmeti, İ.; Motori, D. Antibacterial activity of different extracts of Centaurea cyanus (L.) growing wild in Kosovo. Orient. J. Chem. 2017, 33, 1636–1641. [Google Scholar] [CrossRef]
- Denga, C.; Lib, S.; Feng, C.; Honga, Y.; Huanga, H.; Wanga, J.; Wang, L.; Daia, S. Metabolite and gene expression analysis reveal the molecular mechanism for petal colour variation in six Centaurea cyanus cultivars. Plant Physiol. Biochem. 2019, 142, 22–23. [Google Scholar] [CrossRef]
- Lockowandt, L.; Pinela, J.; Roriza, C.; Pereira, C.; Abreu, R.; Calhelha, R.; Alves, M.; Barros, L.; Bredol, M.; Ferreira, I. Chemical features and bioactivities of cornflower (Centaurea cyanus L.) capitula: The blue flowers and the unexplored non-edible part. Ind. Crops Prod. 2019, 128, 496–503. [Google Scholar] [CrossRef]
- Keyvanloo Shahrestanaki, M.; Bagheri, M.; Ghanadian, M.; Aghaei, M.; Jafari, S.M. Centaurea cyanus extracted 13-O-acetylsolstitialin A decrease Bax/Bcl-2 ratio and expression of cyclin D1/Cdk-4 to induce apoptosis and cell cycle arrest in MCF-7 and MDA-MB-231 breast cancer cell lines. J. Cell. Biochem. 2019, 120, 18309–18319. [Google Scholar] [CrossRef] [PubMed]
- Fernandesa, L.; Pereiraa, J.A.; Saraiva, J.A.; Ramalhosa, E.; Casal, S. Phytochemical characterization of Borago officinalis L. and Centaurea cyanus L. during flower development. Food Res. Int. 2019, 123, 771–778. [Google Scholar] [CrossRef]
- Haratym, W.; Chmielewska, E.; Konarska, A. Microstructural and histochemical analysis of aboveground organs of Centaurea cyanus used in herbal medicine. Protoplasma 2020, 257, 285–298. [Google Scholar] [CrossRef]
- Karamenderes, C.; Khan, S.; Tekwani, B.; Jacob, M.; Khan, I. Antiprotozoal and antimicrobial activities of Centaurea species growing in Turkey. Pharm. Biol. 2006, 44, 534–539. [Google Scholar] [CrossRef]
- Khan, A.B.; Khan, A.; Khan, M.K.; Braga, V. Preparation and properties of high sheared poly(vinyl alcohol)/chitosan blended hydrogels films with Lawsonia inermis extract as wound dressing. J. Drug Deliv. Sci. Technol. 2020, 61, 102227. [Google Scholar] [CrossRef]
- Andrade, P.; Seabra, M.; Valentao, P.; Areias, F. Simultaneous determination of flavonoids, phenolic acids, and coumarins in seven medicinal species by HPLC/diode-array detector. J. Liq. Chromatogr. Relat. Technol. 1998, 21, 2813–2820. [Google Scholar] [CrossRef]
- Mauri, P.; Pietta, P. High performance liquid chromatography/electrospray mass spectrometry of Hypericum perforatum extracts. Rapid Commun. Mass Spectrom. 2000, 14, 95–99. [Google Scholar]
- Tatsis, E.; Boeren, S.; Exarchou, V.; Troganis, A.; Vervoort, J.; Gerothanassis, I. Identification of the major constituents of Hypericum perforatum by LC/SPE/NMR and/or LC/MS. Phytochemistry 2006, 67, 383–393. [Google Scholar] [CrossRef]
- Kajdzanoska, M.; Gjamovski, V.; Stefova, M. HPLC-DAD-ESI-MSn identification of phenolic compounds in cultivated strawberries from Macedonia. Maced. J. Chem. Chem. Eng. 2010, 29, 181–194. [Google Scholar] [CrossRef]
- Zhang, J.; Zhang, Q.; Li, N.; Wang, Z.; Lu, J.; Qiao, Y. Diagnostic fragment-ion-based and extension strategy coupled to DFIs intensity analysis for identification of chlorogenic acids isomers in Flos Lonicerae Japonicae by HPLC-ESI-MSn. Talanta 2013, 115, 1–9. [Google Scholar] [CrossRef]
- Souza, L.; Cipriani, T.; Iacomini, M.; Gorin, P.; Sassaki, G. HPLC/ESI-MS and NMR analysis of flavonoids and tannins in bioactive extract from leaves of Maytenus ilicifolia. J. Pharm. Biomed. Anal. 2008, 47, 59–67. [Google Scholar] [CrossRef] [PubMed]
- Saldanha, L.; Vilegas, W.; Dokkedal, A. Characterization of flavonoids and phenolic acids in Myrcia bella Cambess. using FIA-ESI-IT-MSn and HPLC-PAD-ESI-IT-MS combined with NMR. Molecules 2013, 18, 8402–8416. [Google Scholar] [CrossRef] [PubMed]
- Aksoy, H.; Özakpınar Bingöl, Ö. Yara iyileşmesi ve oksidatif stres. Marmara Pharm. J. 2014, 18, 153–155. [Google Scholar] [CrossRef]
- Gomathi, K.; Gopinath, D.; Ahmed, M.; Jayakumar, R. Quercetin incorporated collagen matrices for dermal wound healing processes in rat. Biomaterials 2003, 24, 2767–2772. [Google Scholar] [CrossRef]
- Samancı Dursun, H.M. TGF-β, Hesperidin ve Kuersetinin MCF-7 Hücresinin uPA Aktivitesi Üzerine ve PAI-1 Ekspresyonuna Etkisi. Master’s Thesis, Selçuklu University, Konya, Türkiye, 2015. [Google Scholar]
- Mutlubaş, H.; Özdemir, Z.Ö. Hypericum perforatum’un geleneksel tıp alanındaki uygulamaları. J. Integr. Anatol. Med. 2020, 1, 10–22. [Google Scholar]
- Yıldırım, M. Effect of kaempferol in medicinal plants on LPS-induced THP-1 macrophages. Mersin Üniversitesi Tıp Fakültesi Lokman Hekim Tıp Tarihi Ve Folk. Tıp Derg. 2023, 13, 118–124. [Google Scholar] [CrossRef]
- Wang, S.; Yao, J.; Zhou, B.; Yang, J.; Chaudry, M.T.; Wang, M.; Xiao, F.; Li, Y.; Yin, W. Bacteriostatic effect of quercetin as an antibiotic alternative in vivo and its antibacterial mechanism in vitro. J. Food Prot. 2018, 81, 68–78. [Google Scholar] [CrossRef]
- Doersch, K.; Rogers, K. The impact of quercetin on wound healing relates to changes in αV and β1 integrin expression. Exp. Biol. Med. 2017, 242, 1424–1431. [Google Scholar] [CrossRef]
- Zheng, Y.; Liang, Y.; Zhang, D.; Sun, X.; Liang, L.; Li, J.; Liu, Y.-N. Gelatin-based hydrogels blended with gellan as an injectable wound dressing. ACS Omega 2018, 3, 4766–4775. [Google Scholar] [CrossRef]
- Alrowaili, Z.A.; Ezzeldien, M.; Mohammed, M.I.; Yahia, I.S. Design of a low-cost laser cut-off filter using carmine dye-doped PVA polymeric composite films. Results Phys. 2020, 16, 103203. [Google Scholar] [CrossRef]
- Jabbar, W.A.; Habubi, N.F.; Chiad, S.S. Optical characterization of silver-doped poly (vinyl alcohol) films. J. Ark. Acad. Sci. 2010, 64, 120–125. [Google Scholar]
- Mohan, P.R.; Sreelakshmi, G.; Muraleedharan, C.V.; Joseph, R. Water soluble complexes of curcumin with cyclodextrins: Characterization by FT-Raman spectroscopy. Vib. Spectrosc. 2012, 62, 77–84. [Google Scholar] [CrossRef]
- Rozylo, R.; Szymanska-Chargor, M.; Gawlik-Gziki, U.; Dziki, D. Spectroscopic, mineral, and antioxidant characteristics of blue-colored powders prepared from cornflower aqueous extracts. Food Chem. 2021, 346, 128889. [Google Scholar] [CrossRef]
- Chopra, H.; Bibi, S.; Kumar, S.; Khan, M.S.; Kumar, P.; Singh, I. Preparation and evaluation of chitosan/PVA-based hydrogel films loaded with honey for wound healing application. Gels 2022, 8, 111. [Google Scholar] [CrossRef]
- Kanjani, B.; Rai, G.; Gilhotra, R.; Kohli, S.; Pandey, V.; Khalsa, R. Formulation design, optimization, and characterization of herbal bioactive-loaded transdermal patch: The state of the art. SGVU J. Pharm. Res. Educ. 2018, 3, 279–288. [Google Scholar]
- Saleem, M.N.; Idris, M. Formulation design and development of a Unani transdermal patch for antiemetic therapy and its pharmaceutical evaluation. Scientifica 2016, 2016, 7602347. [Google Scholar] [CrossRef]
- Tuntiyasawasdikul, S.; Sripanidkulchai, B. Development and clinical trials on anti-inflammatory effect of transdermal patch containing a combination of Kaempferia parviflora and Curcuma longa extracts. J. Drug Deliv. Sci. Technol. 2022, 68, 103093. [Google Scholar] [CrossRef]
- Lan, X.; Liu, Y.; Wang, Y.; Tian, F.; Miao, X.; Wang, H.; Tang, Y. Coaxial electrospun PVA/PCL nanofibers with dual release of tea polyphenols and ε-poly (L-lysine) as antioxidant and antibacterial wound dressing materials. Int. J. Pharm. 2021, 601, 120525. [Google Scholar] [CrossRef]
- Biberoglu, G. Mass spectrometry and medically usage. Türkiye Klin. J. Med. Sci. 2003, 23, 491–498. [Google Scholar]
- Patel, A.V.; Shah, B.N. Transdermal drug delivery system: A review. Int. J. Pharm. Sci. 2018, 9, 378–390. [Google Scholar]
- Sutheesh, T. Formulation and Evaluation of Transdermal Patch of Aqueous Extract of Azadirachta Indica a Juss. Master’s Thesis, The Tamil Nadu Dr. M.G.R. Medical University, Chennai, India, 2017. [Google Scholar]
- Monton, C.; Sampaopan, Y.; Pichayakorn, W.; Panrat, K.; Suksaeree, J. Herbal transdermal patches made from optimized polyvinyl alcohol blended film: Herbal extraction process, film properties, and in vitro study. J. Drug Deliv. Sci. Technol. 2022, 69, 103170. [Google Scholar] [CrossRef]
- Malaiya, M.K.; Jain, A.; Pooja, H.; Jain, A.; Jain, D. Controlled delivery of rivastigmine using transdermal patch for effective management of Alzheimer’s disease. J. Drug Deliv. Sci. Technol. 2018, 45, 408–414. [Google Scholar] [CrossRef]

| Plant | Hypericin Amount (ng mL−1) | Hyperforin (ng mL−1) |
|---|---|---|
| Centaurea cyanus | 12.5 ± 5.2 * | 43.2 ± 0.7 * |
| Sample | E. coli (mm) | S. aureus (mm) |
|---|---|---|
| Centaurea cyanus | 8.2 ± 0.5 * | 16.9 ± 0.8 * |
| Ampicillin | 17.1 ± 0.6 * | 15.8 ± 0.8 * |
| Parameters | Pure PVA Patch | Herbal Patch |
|---|---|---|
| Patch thickness (mm) | 0.147 ± 0.03 * | 0.16 ± 0.03 * |
| Weight uniformity (g) | 0.0555 ± 0.01 * | 0.0775 ± 0.01 * |
| Moisture content percentage (%) | 8.33 * | 10.87 * |
| Humidification percentage (%) | 2.73 * | 3.91 * |
| Surface pH | 6.87 ± 0.03 * | 6.92 ± 0.03 * |
Disclaimer/Publisher’s Note: The statements, opinions and data contained in all publications are solely those of the individual author(s) and contributor(s) and not of MDPI and/or the editor(s). MDPI and/or the editor(s) disclaim responsibility for any injury to people or property resulting from any ideas, methods, instructions or products referred to in the content. |
© 2025 by the authors. Licensee MDPI, Basel, Switzerland. This article is an open access article distributed under the terms and conditions of the Creative Commons Attribution (CC BY) license (https://creativecommons.org/licenses/by/4.0/).
Share and Cite
Abahuni Ucar, M.; Gul, E.M.; Uygunoz, D.; Derun, E.M.; Piskin, M.B. Investigation of PVA Matrix Hydrogel Loaded with Centaurea cyanus Extract for Wound Dressing Applications: Morphology, Drug Release, Antibacterial Efficiency, and In Vitro Evaluation. Gels 2025, 11, 264. https://doi.org/10.3390/gels11040264
Abahuni Ucar M, Gul EM, Uygunoz D, Derun EM, Piskin MB. Investigation of PVA Matrix Hydrogel Loaded with Centaurea cyanus Extract for Wound Dressing Applications: Morphology, Drug Release, Antibacterial Efficiency, and In Vitro Evaluation. Gels. 2025; 11(4):264. https://doi.org/10.3390/gels11040264
Chicago/Turabian StyleAbahuni Ucar, Melis, Enis Muhammet Gul, Deniz Uygunoz, Emek Moroydor Derun, and Mehmet Burcin Piskin. 2025. "Investigation of PVA Matrix Hydrogel Loaded with Centaurea cyanus Extract for Wound Dressing Applications: Morphology, Drug Release, Antibacterial Efficiency, and In Vitro Evaluation" Gels 11, no. 4: 264. https://doi.org/10.3390/gels11040264
APA StyleAbahuni Ucar, M., Gul, E. M., Uygunoz, D., Derun, E. M., & Piskin, M. B. (2025). Investigation of PVA Matrix Hydrogel Loaded with Centaurea cyanus Extract for Wound Dressing Applications: Morphology, Drug Release, Antibacterial Efficiency, and In Vitro Evaluation. Gels, 11(4), 264. https://doi.org/10.3390/gels11040264







